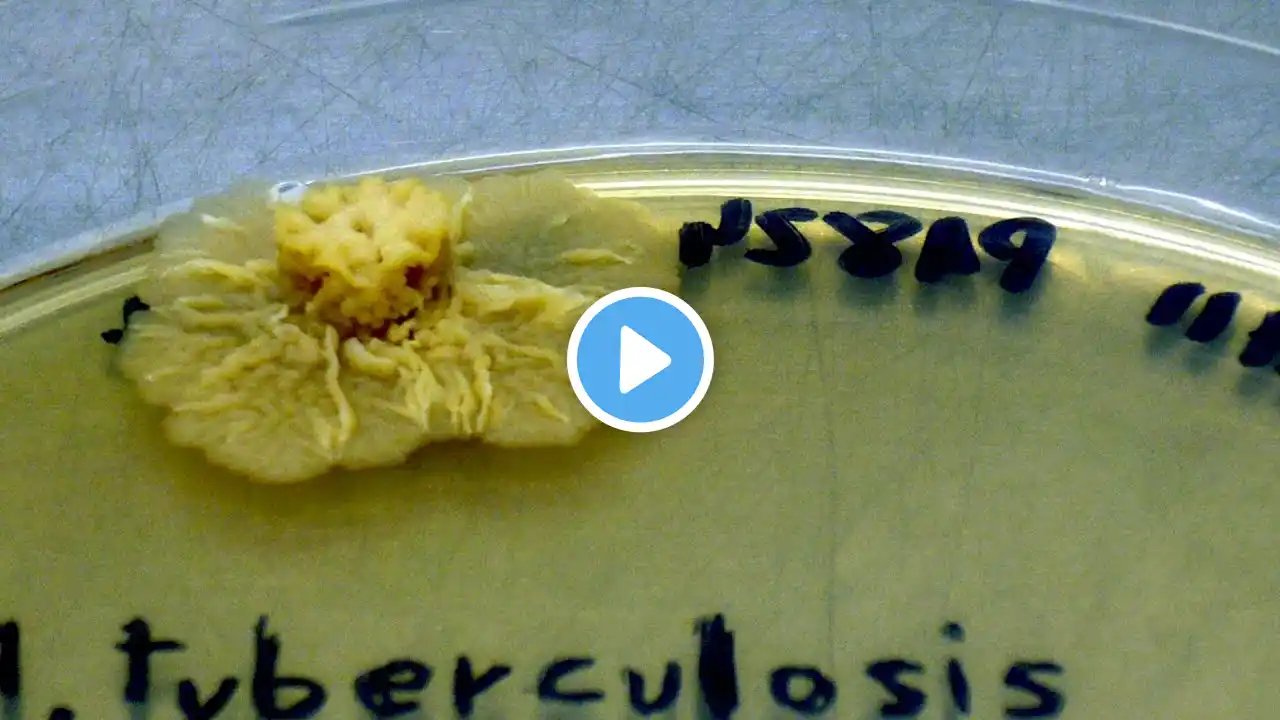
ภาพตัวอย่างวิดีโอ

World TB Day - The burden and re-emergence of TB (part 1 of 6)
Tuberculosis (TB) is a leading cause of morbidity and mortality globally with an estimated 9 million cases and 1.5 million deaths each year. In this video, researchers discuss the burden and re-emergence of tuberculosis. Featuring Ibrahim Abubakar (UCL), Patrick Phillips (UCL), Marc Lipman (Royal Free London) and Helen Fletcher (LSHTM). In recognition of World TB Day 2016, BMC Medicine and BMC Infectious Diseases have launched a series of original research articles, reviews, and commentaries in collaboration with the UCL-TB Centre and the LSHTM TB Centre. The collection includes articles addressing the most up-to-date evidence and innovation in the diagnosis, management and prevention of tuberculosis, as well as particular challenges affecting vulnerable populations. BMC Medicine World TB Day 2016 article collection: http://www.biomedcentral.com/collecti... ************************* Part 2 - • World TB Day - Transmission of TB (part 2 ... Part 3 - • World TB Day - Drug-resistance in TB (part... Part 4 - • World TB Day - Diagnostics and Treatment i... Part 5 - • World TB Day - Immune correlates of TB (pa... Part 6 - • World TB Day - The WHO End TB Strategy (pa... ************************* Music "Day bird" by Broken For Free Available on the Free Music Archive: http://freemusicarchive.org/music/Bro... CC BY 3.0 licence Image credits CDC / Dr. George Kubica, 1976 (Image ID# 4428) National Institute of Allergy and Infectious Diseases (NIAID), 2010 (Image ID# 18139) University College London